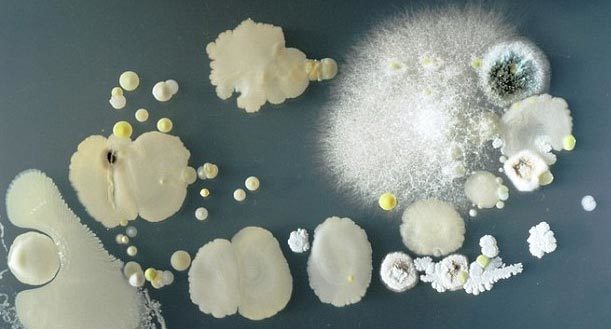
{keywords}

Nếu bạn hiếm khi xa rời chiếc điện thoại di động thông minh (smartphone), nhiều khả năng bạn đang lưu giữ các vi khuẩn lúc nhúc quanh mình, như những hình ảnh đáng sợ vừa được hé lộ trong nghiên cứu mới đây.

Trong một số trường hợp, các vi khuẩn tương đối vô hại và bắt nguồn từ việc điện thoại chạm vào các bề mặt không sạch sẽ hoặc chủ nhân không rửa tay đúng cách. Tuy nhiên, trong một số trường hợp khác, các vi khuẩn bám vào bề mặt smartphone có thể dẫn đến các bệnh nhiễm trùng, chẳng hạn như chứng ngộ độc thực phẩm, bệnh chốc lở và thậm chí cả nhiễm trùng máu.

Để nghiên cứu về mức độ bẩn trên điện thoại di động của một người, tiến sĩ Simon Park, một giáo sư chuyên ngành vi trùng học tại Đại học Surrey (Anh) đã yêu cầu các sinh viên in smartphone của họ lên "môi trường phát triển vi khuẩn" trong các đĩa Petri thí nghiệm.
Sau 3 ngày, họ tiến hành xem xét các vi khuẩn sinh sổi nảy nở trong các đĩa và sốc nặng trước những gì họ quan sát được.
Trong nhiều mẫu thu được, nhóm nghiên cứu đã phát hiện các vi khuẩn mang bệnh Staphylococcus aureus. Ước tính mầm bệnh này thường xuyên ẩn náu trên cơ thể của khoảng 20% người trong chúng ta.
Nhiều người khỏe mạnh thường xuyên mang theo Staphylococcus aureus trên da và trong mũi của họ mà không phát bệnh. Tuy nhiên, khi da bị sứt sẹo, loại vi khuẩn này có thể xâm nhập vào trong vết thương và gây viêm nhiễm. Hậu quả phổ biến của việc nhiễm trùng Staph có thể là chốc lở, nhiễm độc thực phẩm và thậm chí nhiễm trùng máu nghiêm trọng.

Theo các chuyên gia, vi khuẩn Staphylococcus aureus có thể lan truyền dễ dàng thông qua các bề mặt nhiễm khuẩn hoặc từ người sang người.
Một loại vi khuẩn khác cũng được phát hiện sống bám trên điện thoại di động là Bacillus mycoides. Do loại vi khuẩn này cư trú phổ biến trong đất, nên nó ám chỉ người sử dụng hoặc bản thân chiếc điện thoại di động mới đây đã tiếp xúc với đất.
Bacillus mycoides hiện đang được sử dụng trong nhiều loại thuốc trừ sâu phổ biến trên thị trường, nhằm ức chế sự phát triển của các vi khuẩn và nấm mốc gây hại.

"Dường như điện thoại di động không chỉ ghi nhớ các số điện thoại, mà còn lưu giữ lịch sử các tiếp xúc cá nhân và thể chất của chúng ta, chẳng hạn như con người, đất hay vật chất khác", tiến sĩ Park nói.
Các thử nghiệm gần đây từng hé lộ, một chiếc di động bình thường dung chứa số vi khuẩn tiềm tàng gây hại cao gấp 18 lần một cần gạt nước trong toilet của nam giới. Trong khi đó, một cuộc kiểm tra các cần gạt nước toilet phát hiện, gần 1/4 số chúng bẩn đến mức là ổ chứa vi khuẩn cao gấp 10 lần ngưỡng cho phép.
Tuấn Anh (Theo Daily Mail)